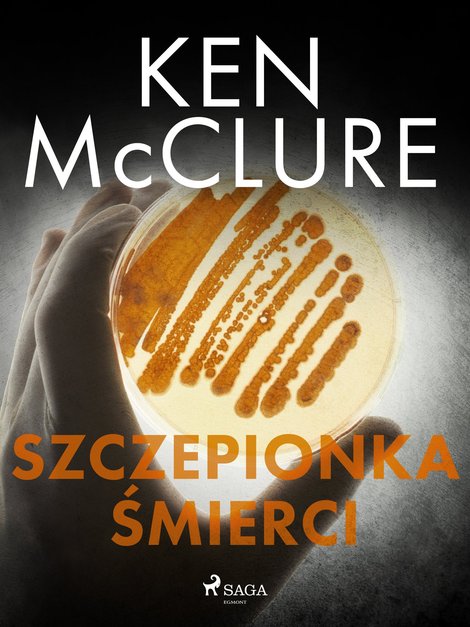
ebooki: Szczepionka śmierci – ebook

Szczepionka śmierci – ebook
Czy trzeba bać się kolejnej pandemii i szczepić się przed nowym wariantem ,,hiszpanki", która w 1918 r. zabiła 40 mln. ludzi? Kiedy w laboratorium trwają prace nad szczepionką przeciwko grypie, znienacka wpada tam banda ,,ekologów", która bestialsko morduje jednego z zatrudnionych w nim naukowców. Dr Steven Dunbar próbuje ustalić przyczyny zabójstwa w tajnym instytucie i wyjaśnić, co tak naprawdę tam planowano. Gdy w jego otoczeniu giną kolejni ludzie, hipoteza o pracach nad rekonstrukcją szczepu ,,hiszpanki" staje się coraz bardziej prawdopodobna. ,,Szczepionka" to szósty z thrillerów o śledztwach dra Dunbara, można go uznać za oddzielną historię lub czytać bez zachowania kolejności serii. Jeśli lubisz mrożące krew w żyłach intrygi w thrillerach medycznych i pasjonuje cię tematyka broni biologicznej, ,,Szczepionka śmierci" na pewno trafi w twój gust czytelniczy.
Bądź pierwszą osobą, która doda opinię!